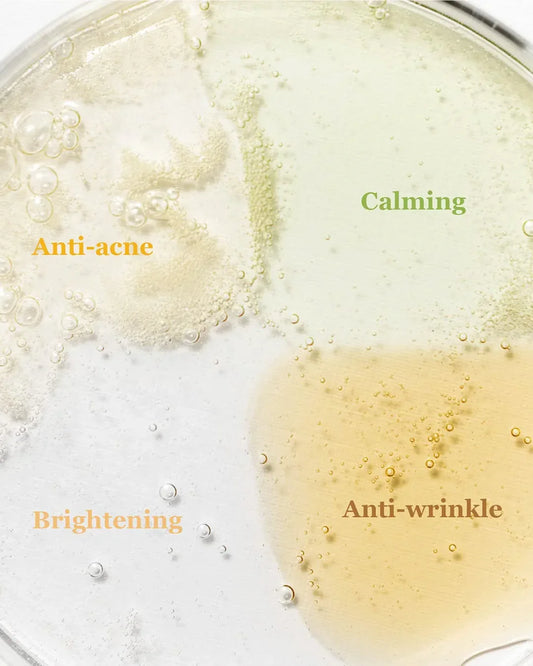
HandBag Serum Discovery Kit - Beauty of Joseon

Colección: Productos
-
Hand balm - Sephora
Precio habitual L 260.00 HNLPrecio habitualPrecio unitario / porPrecio de oferta L 260.00 HNL -
Hand Cream shea butter - Bath & Body Works
Precio habitual L 220.00 HNLPrecio habitualPrecio unitario / porPrecio de oferta L 220.00 HNLAgotado -
Hand Mist Case - Touchland x Crocs
Precio habitual L 780.00 HNLPrecio habitualPrecio unitario / porPrecio de oferta L 780.00 HNL -
HandBag Serum Discovery Kit - Beauty of Joseon
Precio habitual L 615.00 HNLPrecio habitualPrecio unitario / porPrecio de oferta L 615.00 HNLAgotado -
AgotadoHangover 3-in-1 Too Faced
Precio habitual L 650.00 HNLPrecio habitualPrecio unitario / porPrecio de oferta L 650.00 HNLAgotado -
Hangover Replenish Face primer Too Faced
Precio habitual A partir de L 700.00 HNLPrecio habitualPrecio unitario / porPrecio de oferta A partir de L 700.00 HNLAgotado -
AgotadoHangoverx Pillow Balm Too Faced
Precio habitual L 590.00 HNLPrecio habitualPrecio unitario / porL 700.00 HNLPrecio de oferta L 590.00 HNLAgotado -
AgotadoHAUS Laboratories by Lady Gaga
Precio habitual L 750.00 HNLPrecio habitualPrecio unitario / porPrecio de oferta L 750.00 HNLAgotado -
Hd Skin Blush & Glow Palette - Make Up For Ever Profesional Paris
Precio habitual L 2,750.00 HNLPrecio habitualPrecio unitario / porPrecio de oferta L 2,750.00 HNLAgotado -
HD Skin Face Essentials Palette - Make Up For Ever Professional Paris
Precio habitual L 2,980.00 HNLPrecio habitualPrecio unitario / porPrecio de oferta L 2,980.00 HNLAgotado -
HD skin Twist & Light Loose Powder - Makeup For Ever
Precio habitual L 1,490.00 HNLPrecio habitualPrecio unitario / porL 1,650.00 HNLPrecio de oferta L 1,490.00 HNLOferta -
Heartleaf 77% Soothing Toner - Anua
Precio habitual A partir de L 180.00 HNLPrecio habitualPrecio unitario / porPrecio de oferta A partir de L 180.00 HNL -
OfertaHeartleaf Essence - Mixsoon
Precio habitual L 395.00 HNLPrecio habitualPrecio unitario / porL 590.00 HNLPrecio de oferta L 395.00 HNLOferta -
Heartleaf Pore Control Cleansing Oil - Anua
Precio habitual L 595.00 HNLPrecio habitualPrecio unitario / porPrecio de oferta L 595.00 HNL -
Heartleaf Pore Control Cleansing Oil Mild - Anua
Precio habitual L 595.00 HNLPrecio habitualPrecio unitario / porPrecio de oferta L 595.00 HNL -
Heartleaf Pore Deep Cleansing Foam - Anua
Precio habitual L 490.00 HNLPrecio habitualPrecio unitario / porPrecio de oferta L 490.00 HNL -
Heartleaf Soothing Trial Kit - Anua
Precio habitual L 695.00 HNLPrecio habitualPrecio unitario / porPrecio de oferta L 695.00 HNL -
Heat Protector - Sun Bum
Precio habitual L 695.00 HNLPrecio habitualPrecio unitario / porPrecio de oferta L 695.00 HNL -
Heat-Free Satin Hair Curling Rod Set-AOA
Precio habitual L 195.00 HNLPrecio habitualPrecio unitario / porPrecio de oferta L 195.00 HNL -
Heavy Metal Eye Liner - Urban Decay
Precio habitual L 750.00 HNLPrecio habitualPrecio unitario / porPrecio de oferta L 750.00 HNLAgotado